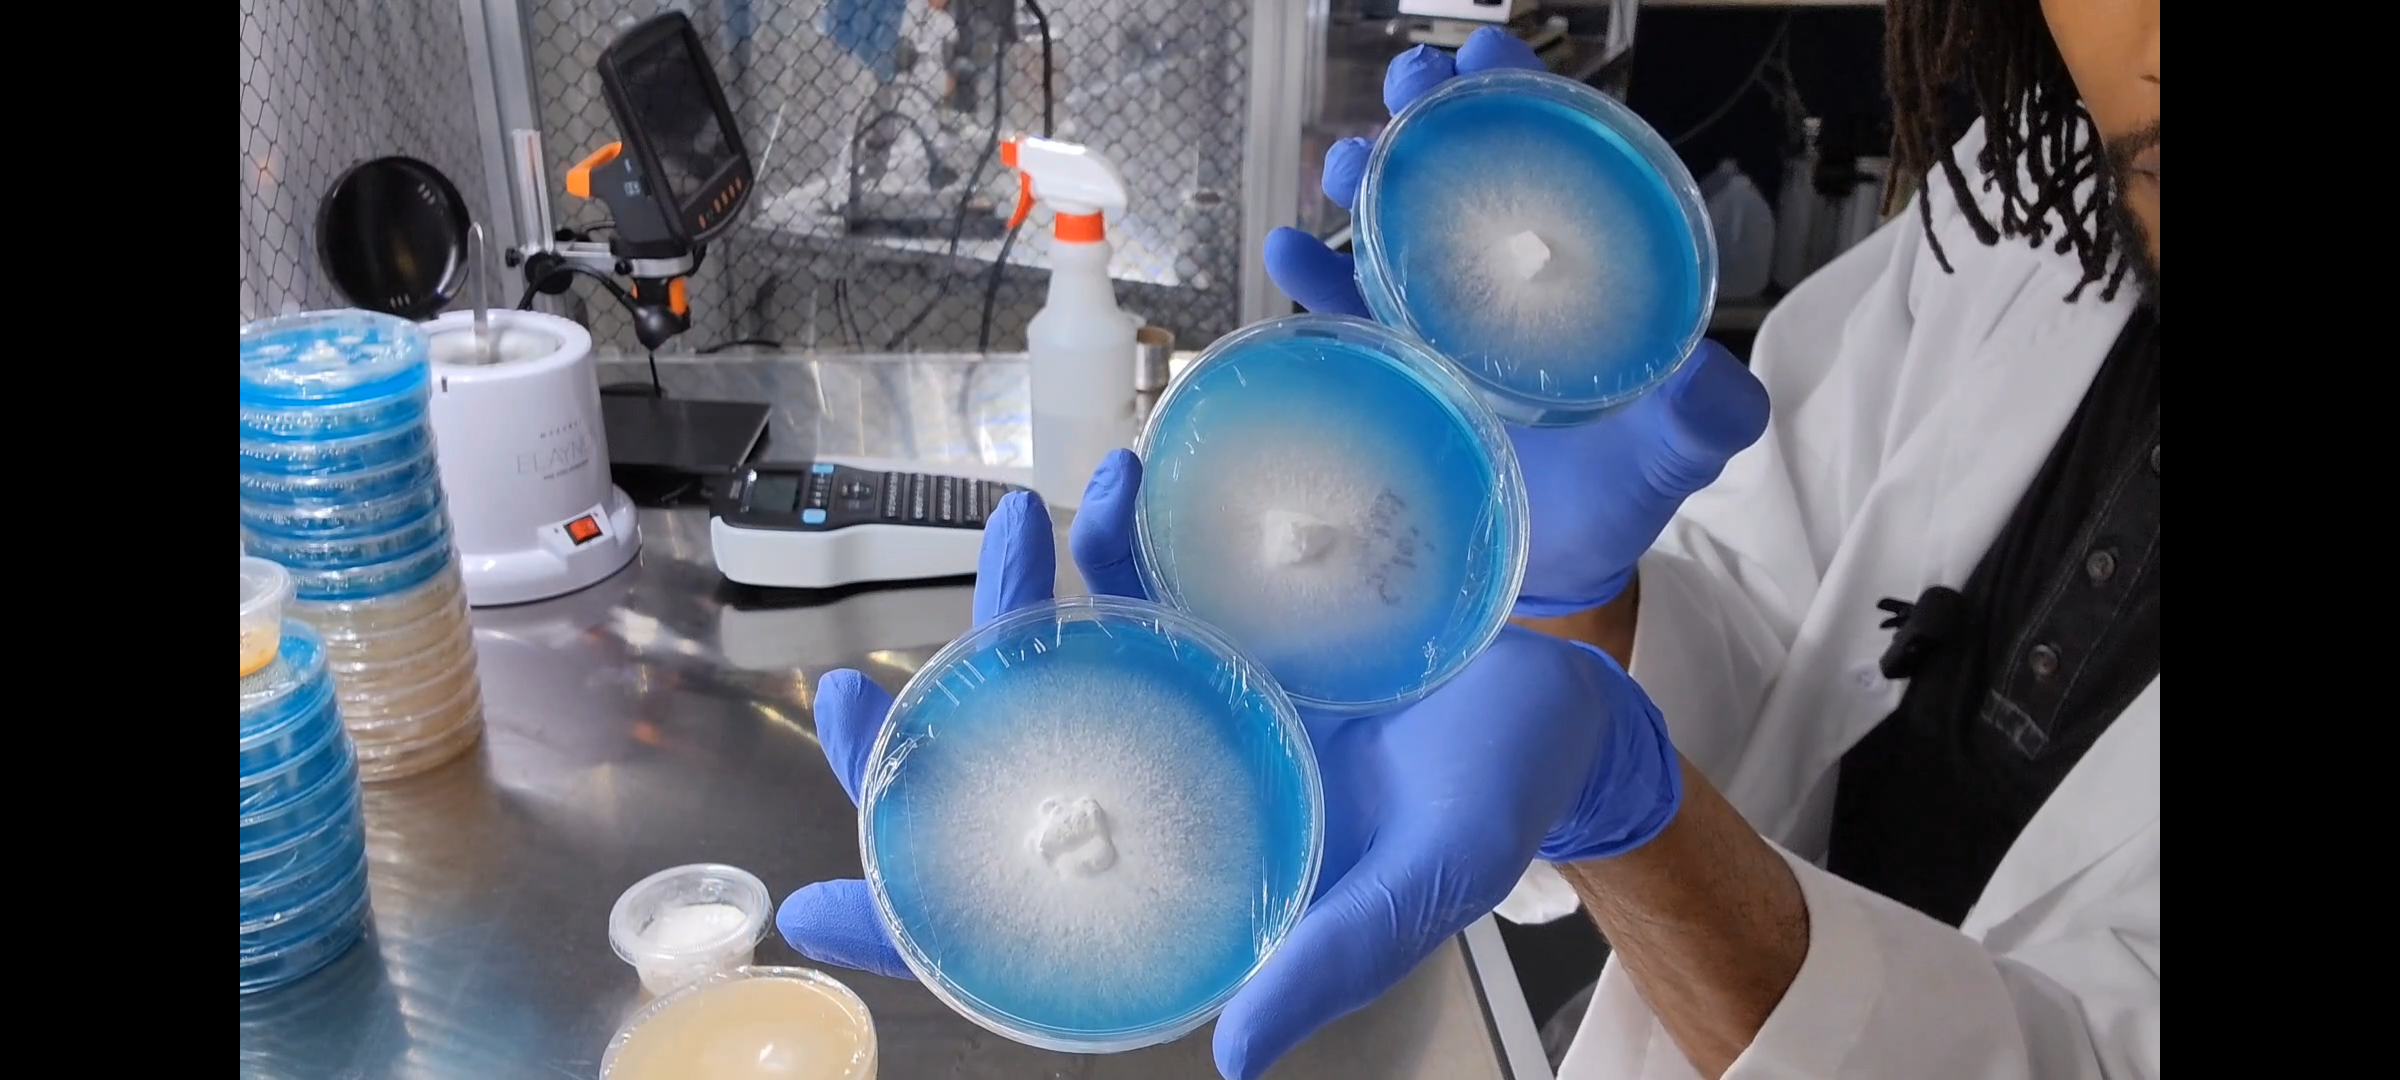

Fungi Culture Library
Take a look behind the scenes at some of our Culture Library and the stories behind them!

Hericium Erinaceus
The 'ROAR' Strain
This particular variety was foraged and cloned December of 2022 by us and was the first wild Lion's Mane we ever foraged! Found near Shirlington Dog Park in Virginia.
Straight after cloning this, it was on par with many commercial strains in terms of substrate colonization, fruiting potential, and efficiency. Produces dense but fluffy fruiting bodies and doesn't mind heat despite being foraged in Winter!
ROAR is our premier fungi and has given us hundreds of pounds of great fruit. Stumbling upon it when we did was a blessing in disguise!

Ganoderma sessile
The Queen
This Reishi was sampled and cloned by us July of 2023 and is the one of the largest Ganoderma species we've ever seen!
The culture was an easy isolation and cleaning since it was so fresh, and is as aggressive as you might imagine. I've seen it colonize oak substrate at a 1:5 ratio in 4 days!
One of our favorites here at Mycrodex as she's reliable and very quick to produce fruit!

Ganoderma Curtisii
Umbra, The Rare
This beautiful specimen was spotted by myself in someone's back yard in August of 2024.
After getting permission from the home owners (a very friendly married couple), I quickly identified this as G. curtisii based on the morphology and purple hues. I've since named her Umbra 💜.
The mycelium pulled from the shell are insanely fast at colonizing substrate and it fruits just as quickly, even performing both simultaneously! This has quickly become my favorite subspecies of Ganoderma because of the unique morphology and color striations.

Ischnoderma Resinosum
Anise, The Resinous
This specimen was found in Rock Creek Park in Washington D.C. There were over 20lbs of this amazing fungi and we harvested enough for extractions and a cloning.
The nickname 'Anise' comes from the very loud scent that emanates from not only the fruiting body, but also the mycelium itself! It is very reminiscent of star anise and marshmallows. With this being an edible species, the ideas are endless as the flavor profile is incredibly unique.
This species likes low oxygen, high CO2, and lots of moisture, otherwise it will hibernate!

Hericium Erinaceus
The Bandit
This variety of Hericium was foraged and cloned November of 2024. It was found near 'Bandit Taco' by U Street NW in Washington DC, hence the name! It was also named 'Bandit' because of its fruiting placement . Needed to climb the tree to get this one!
The mycelium of this sample was extremely young! The fruiting body was still fresh for cloning and it seemed to have been a somewhat new germination.
We eventually phased this variety out, as the ROAR strain out-competed it in every avenue, but it was still a great learning experience.

Hericium Erinaceus
The Brick
Back in November of 2023, I stumbled upon this massive fruiting of a Lion's Mane mushroom that was protruding from a tree near the National Academy of Science in Washington D.C.
I was blown away at the sight and made a video showcasing the spectacle, leading to a viral video with over 200,000 views!
The trees in the area were pretty ancient, and I came to the conclusion that the mycelium was too as it performed very poorly in every medium I put it on.
Still, an amazing experience that I enjoyed sharing with everyone!

Panus iecomtei
The Hairy Oyster
On June 27th, 2025 I was driving in NW Washington D.C. and happened to spot a patch of Reishi in the tall grass. When I got out of the car to investigate, I was met with a species I had only seen once before, but couldn't clone it due to how thin and dry it was.
Quickly grabbed my phone to document this and took it straight home to clone and it ended up just barely being a success, and my documented video went viral with over 440,000 views!
Since then, I have worked with other friends in the Mycology community to sequence the genome of this specimen, cloned the mycelium to produce pounds more of it, and have even bred the offspring of the original sample!
This beautiful, unique, and tasty fungi has taught us a lot about mushrooms in general and is in my Top 3 favorites to have cultivated!
We also FULLY documented its discovery, isolation from contamination, cloning, and breeding on our social media accounts!